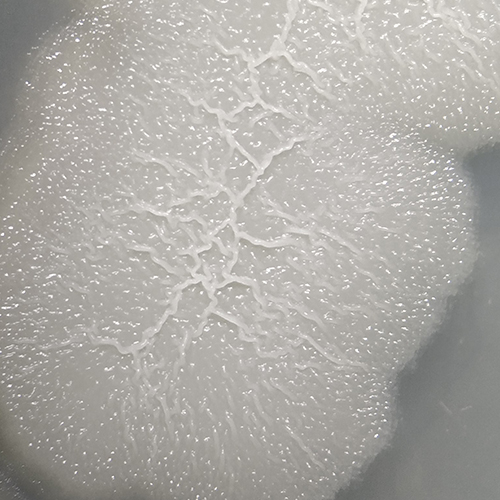

Brazil is a global leader in soybean production and exports, driving the economy and strengthening agribusiness across multiple regions. Soybeans play a strategic role in the global economy, supporting agribusiness and meeting growing demands for food, biofuels and industrial raw materials.
At Vittia, we offer integrated solutions that support every stage of the soybean production cycle, meeting its specific requirements. Our products enhance crop performance through advanced technologies in nutrition, biological control and integrated pest and disease management.
Main products
Check out some related products below